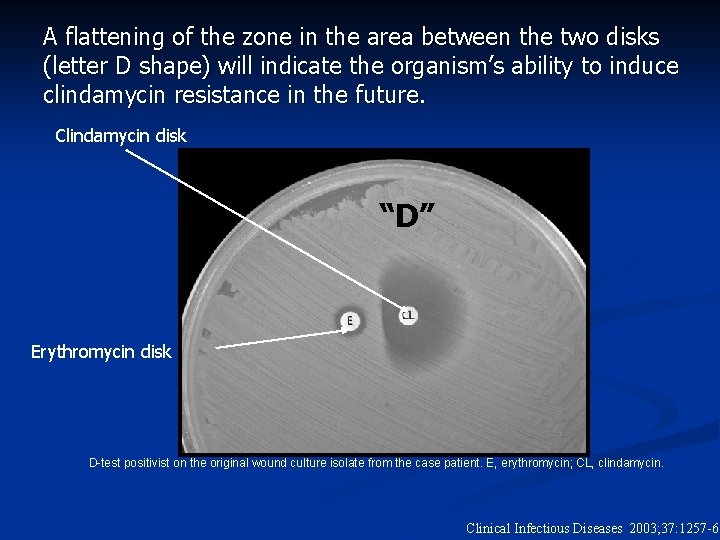
A flattening of the zone in the area between the two disks (letter D
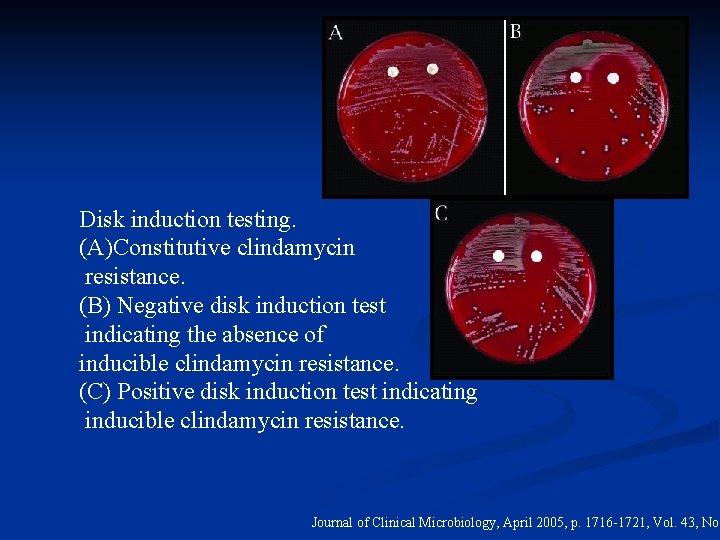
Disk induction testing. (A)Constitutive clindamycin resistance. (B) Negative disk induction test indicating the absence

Clindamycin induction test in treating patients infected with

- Slides: 31
Clindamycin induction test in treating patients infected with methicilin resistant Staphylococcus aureus Presented by Iyad Kaddora
Staphylococcus aureus n n n n Belongs to Micrococcaceae family. Gram positive cocci. Clusters resembling grape. Part of the humans normal flora. Exist in air and water. Number one cause of nosocomial infections. Approximately 25% to 30% of the population is colonized.
Staphylococcus aureus images Health info. 2005
S. aureus Virulence Factors n n n Surface proteins Invasions Surface factors Biochemical properties Exotoxins Inherent and acquired resistance to antimicrobial agents molbio. princeton. university
40% of nosocomial S. aureus infections are methicillin resistant First reported in 1960 s n Causes severe morbidity and mortality worldwide n Endemic in many European and American hospitals n Many in-patients are colonized or infected n 25% hospital personnel may be carriers n Spread by hand, usually of health care workers n
Risk factors for methicilin resistant Staphylococcus aureus colonization Advanced age n Male gender n Previous hospitalization n Length of hospitalization n Chronic medical illness n Prior and prolonged antibiotic therapy n Presence and size of a wound n Exposure to colonized or infected patient n
Proportion of nosocomial MRSA among the intensive care unit patients NNIS System.
Rates of hospital MRSA isolates from 324 geographically distributed US health care institutions in year 2003 Pfizer. © 2005 Pfizer Inc.
Antibiotics Resistance Antibiotics are used to treat bacterial infections, but recently they start becoming less effective. n In the past few years S. aureus has began to show more resistant to commonly used antibiotics. n S. aureus has developed new strains called methicilin resistant Staphylococcucs aureus (MRSA). n Methcilin resistance now refers to multiantibiotic resistant group. n
Clindamycin antibiotic is drug of choice for treating patients infected with MRSA Clindamycin n β-lactam antibiotic. n Inhibits the synthesis of protein in bacterial organism. n Prevents the bacteria from replicating. The failure of clindamycin treatment to MRSA infected patients, raises a big concern to health care professional and attending physicians.
Antibiotics resistance mechanisms The resistance to erythromycin and clindamycin occurs by one of two mechanisms. n Efflux: typically mediated by msr. A gene. n Ribosome alteration: occur through methylation of the ribosomal target site, and this resistance is mediated by erm gene. n
Objective: n Many studies have been performed regarding MRSA. n New test has been developed to test the future resistance of MRSA strains to clindamycin. n The hypotheses: MRSA strains are becoming more resistant to clindamycin during 2004/2005 year compared to 2000/2001.
Materials and methodology n n The testing specimens were collected in year 2000/2001, and year 2004/2005. The specimens were saved in order to be evaluated for clindamycin resistance. D test is performed on MRSA strains from sources other than urine. MRSA has to be erythromycin resistant and clindamycin sensitive.
The D Test D test is way to detect inducible clindamycin resistance. n In order for the resistance to show up inducing agent is required. n D test output: 1. Positive D test. 2. Negative D test. n
D-test principle n n n D test is done to allow erythromycin induce production of methylase. Erythromycin ribosome methylase is a gene that encodes enzymes which confer inducible or constitutive resistance to clindamycin. Induced clindamycin resistance is detected by forming a D shape letter on the agar plate.
A flattening of the zone in the area between the two disks (letter D shape) will indicate the organism’s ability to induce clindamycin resistance in the future. Clindamycin disk “D” Erythromycin disk D-test positivist on the original wound culture isolate from the case patient. E, erythromycin; CL, clindamycin. Clinical Infectious Diseases 2003; 37: 1257 -60
D test procedure: Make 0. 5 Mc. Farland suspensions (turbidity measurement) in 3 ml sterile inoculum’s water. n Sterile swab is used to inoculate the organism to blood agar plate. n Place an erythromycin disk 15 to 26 mm away from the clindamycin disk, in the blood agar plate. n Incubate 18 -24 hours at 35°C. n
Disk induction testing. (A)Constitutive clindamycin resistance. (B) Negative disk induction test indicating the absence of inducible clindamycin resistance. (C) Positive disk induction test indicating inducible clindamycin resistance. Journal of Clinical Microbiology, April 2005, p. 1716 -1721, Vol. 43, No.
Results of the D test - All clinical S. aureus Isolates at the Johns Hopkins Hospi - Nov 1, 2002 through Dec 17, 2002 - 512 Total S. aureus Isolates Clinical Infectious Diseases 2003; 37: 1257 -60
Clindamycin Susceptibility Testing for Adult & Pediatric S. aureus Isolates Discordant Susceptibility • Adult: 36% • 17% i. MLS • Pediatric: 32% • 20% i. MLS Clinical Infectious Diseases 2003; 37: 1257 -60
Clindamycin Susceptibility Testing for MRSA Clinical Infectious Diseases 2003; 37: 1257 -60
Reported Frequency of In Vitro Inducible Resistance to Clindamycin in MRSA Report Location (Pediatric vs. Adult) Subject for Dtest Positive D-test Como-Sabetti Minnesota (Not specified) Chicago (Pediatric) 64% of all MRSA 84% 38% of all MRSA 94% Houston (Pediatric) 90% of all MRSA 8% Ped: 25% Ad: 44% 43% 51% IDSA 2002 #92 Frank PIDJ 2002; 21: 530 Sattler PIDJ 2002; 21: 910 Current Study Baltimore (combined) Clinical Infectious Diseases 2003; 37: 1257 -60
Clindamycin treatment of MRSA infections § 31/33 were D test positive § 9/31 treated with clindamycin n 1 could not be evaluated n 3 received multiple antibiotics n 5 treated with clindamycin only 3/5: minor skin infections resolved on clindamycin 2/5: clinical failures on clindamycin Frank PIDJ 2002; 21: 530.
Lab Protocol for S. aureus cultured MRSA MSSA Clinda R or Clinda S and Eryth S/Clinda S Erythro R Routine D-test Report Clinda MIC + Clinda S and Erythro R Clinda R or Eryth. S /Clinda S D-test at request of Physician + Report Clinda=R Report Clinda MIC
Clindamycin Treatment of S. aureus Infections n MRSA n Important therapeutic option if n Erythromycin and clindamycin sensitive n Erythromycin-resistant, clindamycin sensitive IF D-test negative n MSSA Beta lactam more widely used n Concern for treatment failure same as for MRSA, if clindamycin S, erythromycin R, D test positive n
Clinical Significance of In Vitro Inducible Resistance to Clindamycin n n Increasing use of clindamycin for MRSA Importance of awareness of potential for increased risk of treatment failure with positive D test: n MRSA & MSSA n Rates of positive D test in S. aureus may varies by age, region, time n D-test erythromycin R/ clindamycin S MRSA & MSSA before reporting clindamycin susceptibility
Conclusion n The high frequency of positive D test for MSSA isolates raises concern that clindamycin may fail to treat MSSA. n Clindamycin should be avoided as a treatment for patients infected by S. aureus exhibiting inducible resistance n The proportion of S. aureus with in vitro inducible clindamycin resistance may vary by region, age group, and methicillin sensitivity
Conclusion n There has been a marked increase in the number of patients with infections that are unreceptive to clindamycin treatment. n The large number of positive D test may explain the failure of clindamycin in treating the infected patients. n This study has demonstrated the importance of performing D test on MRSA Isolates.
Future studies Is it gender specific? n Is it age specific? n Repeated infections? n Environment effects? n Molecular mechanism of antibiotics resistance? n Improving the D test. n
Acknowledgment Dr. Harrison n BSC 661 n
Questions?